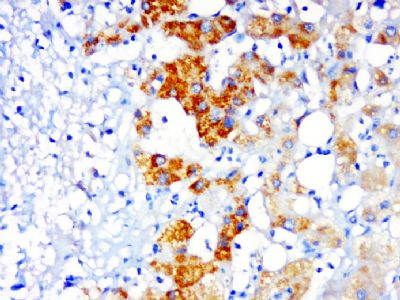
产品细节图片1

相关产品推荐更多 >
万千商家帮你免费找货
0 人在求购买到急需产品
- 详细信息
- 文献和实验
- 技术资料
- 供应商:
上海联迈生物工程有限公司
- 库存:
大量
- 目录编号:
LM-19469R
- 克隆性:
多克隆
- 抗原来源:
Rabbit
- 保质期:
1年
- 抗体英文名:
PSMD14
- 抗体名:
蛋白酶调解因子14抗体
- 宿主:
Rabbit
- 适应物种:
Human, Mouse, Rat, Chicken, Pig, Cow, Horse, Rabbit, Zebrafish, Sheep,
- 免疫原:
KLH conjugated synthetic peptide derived from human PSMD14:221-310/310
- 亚型:
IgG
- 形态:
Lyophilized or Liquid
- 应用范围:
ELISA=1:500-1000 IHC-P=1:400-800 IHC-F=1:400-800 ICC=1:100-500 IF=1:100-500 (石蜡切片需做抗原修复)
- 浓度:
1mg/ml
- 保存条件:
Store at -20 °C
- 规格:
100ul 200ul
| 英文名称 | PSMD14 |
| 中文名称 | 蛋白酶调解因子14抗体 |
| 别 名 | 26S proteasome non-ATPase regulatory subunit 14; 26S proteasome regulatory subunit rpn11; 26S proteasome-associated PAD1 homolog 1; 26S proteasome-associated PAD1 homolog; PAD1; PAD1, yeast, homolog of; POH1; Proteasome (prosome, macropain) 26S subunit, non-ATPase, 14; Proteasome 26S subunit non ATPase 14; PSDE_HUMAN; Psmd14; RPN11. |
| 规格价格 | 100ul/1380元 购买 200ul/2200元 购买 大包装/询价 |
| 说 明 书 | 100ul 200ul |
| 研究领域 | 细胞生物 转录调节因子 表观遗传学 泛素 |
| 抗体来源 | Rabbit |
| 克隆类型 | Polyclonal |
| 交叉反应 | Human, Mouse, Rat, Chicken, Pig, Cow, Horse, Rabbit, Zebrafish, Sheep, |
| 产品应用 | ELISA=1:500-1000 IHC-P=1:400-800 IHC-F=1:400-800 ICC=1:100-500 IF=1:100-500 (石蜡切片需做抗原修复) not yet tested in other applications. optimal dilutions/concentrations should be determined by the end user. |
| 分 子 量 | 35kDa |
| 细胞定位 | 细胞核 细胞浆 |
| 性 状 | Lyophilized or Liquid |
| 浓 度 | 1mg/ml |
| 免 疫 原 | KLH conjugated synthetic peptide derived from human PSMD14:221-310/310 |
| 亚 型 | IgG |
| 纯化方法 | affinity purified by Protein A |
| 储 存 液 | 0.01M TBS(pH7.4) with 1% BSA, 0.03% Proclin300 and 50% Glycerol. |
| 保存条件 | Store at -20 °C for one year. Avoid repeated freeze/thaw cycles. The lyophilized antibody is stable at room temperature for at least one month and for greater than a year when kept at -20°C. When reconstituted in sterile pH 7.4 0.01M PBS or diluent of antibody the antibody is stable for at least two weeks at 2-4 °C. |
| PubMed | PubMed |
| 产品介绍 | background: This gene encodes a component of the 26S proteasome. The 26S proteasome is a large multiprotein complex that catalyzes the degradation of ubiquitinated intracellular proteins. The encoded protein is a component of the 19S regulatory cap complex of the 26S proteasome and mediates substrate deubiquitination. A pseudogene of this gene is also located on the long arm of chromosome 2. [provided by RefSeq, Feb 2012] Function: Metalloprotease component of the 26S proteasome that specifically cleaves 'Lys-63'-linked polyubiquitin chains. The 26S proteasome is involved in the ATP-dependent degradation of ubiquitinated proteins. The function of the 'Lys-63'-specific deubiquitination of the proteasome is unclear. Tissue Specificity: Widely expressed. Highest levels in heart and skeletal muscle. Similarity: Belongs to the peptidase M67A family. PSMD14 subfamily. Contains 1 MPN (JAB/Mov34) domain. SWISS: O00487 Gene ID: 10213 Database links: Entrez Gene: 10213 Human Entrez Gene: 59029 Mouse Entrez Gene: 311078 Rat Omim: 607173 Human SwissProt: O00487 Human SwissProt: O35593 Mouse Unigene: 567410 Human Unigene: 218198 Mouse Unigene: 161794 Rat Important Note: This product as supplied is intended for research use only, not for use in human, therapeutic or diagnostic applications. |
| 产品图片 | ![]() Paraformaldehyde-fixed, paraffin embedded (liver cancer); Antigen retrieval by boiling in sodium citrate buffer (pH6.0) for 15min; Block endogenous peroxidase by 3% hydrogen peroxide for 20 minutes; Blocking buffer (normal goat serum) at 37°C for 30min; Antibody incubation with (NTF2) Polyclonal Antibody, Unconjugated (bs-19496R) at 1:500 overnight at 4°C, followed by a conjugated secondary (sp-0023) for 20 minutes and DAB staining. |
风险提示:丁香通仅作为第三方平台,为商家信息发布提供平台空间。用户咨询产品时请注意保护个人信息及财产安全,合理判断,谨慎选购商品,商家和用户对交易行为负责。对于医疗器械类产品,请先查证核实企业经营资质和医疗器械产品注册证情况。
文献和实验饥饿的 HeLa 和 NIH 3T3 癌细胞系获得的裂解物中的磷酸化蛋白特异性。图示:从复杂生物样品中富集高纯度磷蛋白。用 theThermo Scientific Pierce 磷酸化蛋白富集试剂盒进行 Weste blot 分析,根据试剂盒说明书制备细胞裂解液,富集磷酸化蛋白。利用识别生长因子信号传导相关关键调控蛋白的磷酸化特异性抗体实现蛋白检测。细胞色素 C (pI 9.6) 和 p15Ink4b (pI 5.5) 作为非磷酸化蛋白非特异性结合的阴性对照。FT = 流穿馏分,W = 合并洗脱馏分,E
【求助】P53的翻译后修饰都有哪些? 怎样验证其修饰后与靶标启动子的结合活性的变化?
可通过p53结合蛋白PRMT1和CARM1(辅助活化因子相关的精氨酸甲基转移酶)相互作用获得。当靶基因的转录激活不再需要p53时去乙酰化作用可以作为一种快速的调节机制来抑制p53的功能。 泛素化修饰 正常细胞中降解是消除p53功能的唯一机制,这种降解部分是由泛素-26S蛋白酶体系统完成的(其它途径是非泛素依赖性的)。泛素是一种高度保守的蛋白质,靶向作用于底物蛋白,使其被26S蛋白酶体降解成多肽。泛素连接酶实现了泛素化修饰的最后一步,这些酶显示出一种高水平的靶向特异性。正常
染色质免疫沉淀(Chromatin Immunoprecipitation, ChIP)是研究体内(划重点鸭,体内)蛋白质与DNA相互作用的一种技术。它利用抗原抗体反应的特异性,可以真实地反映体内蛋白因子与基因组DNA结合的状况。可应用于组蛋白修饰、DNA复制与损伤相关因子结合分析、干细胞调控转录因子及辅因子等基因表达机制的广泛研究。 最近有做chIP的朋友来找我们咨询: 为什么我的ChIP实验做出来, 结果就是不理想呢? 为得到理想的ChIP结果,可以做以下实验条件优化: 1、 染色
技术资料暂无技术资料 索取技术资料